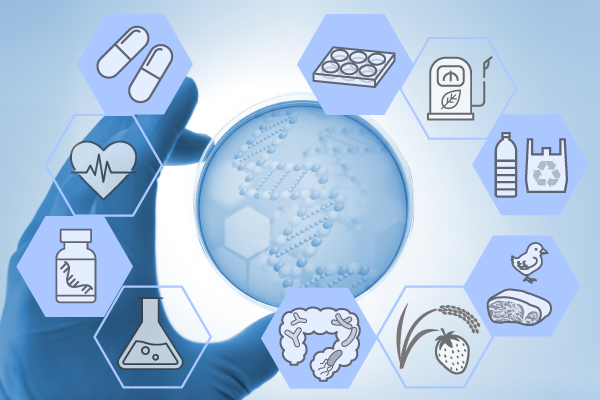
スマート育種・バイオ生産部門

スマート育種・バイオ生産部門
部門概要
工・農・医・薬の知を融合させ、SDGs、健康寿命、QOLへの貢献を目指す
資源不足に起因する低いエネルギー自給率と化石燃料への高度依存、超少子高齢社会の進行による労働力人口の減少と医療費の増大、異常気象に伴う食料の供給不安定など、我々の生活をとりまく環境は深刻化しています。スマート育種・バイオ生産部門では、スマートセルによる種の改良の効率化と精密化、生体由来物質利用による新規バイオ医薬品の創出、農畜水産物素材の能力強化による保健機能食品の開発などに取り組んでいます。工・農・医・薬の知を融合させた3つのグループが、SDGs、健康寿命、QOLへの貢献を目指し、先端研究を展開しています。

研究分野
バイオ燃料・化学品分野
持続可能な低炭素社会の実現を目指し、生物資源を利用したバイオ製造プロセスの開発に取り組んでいます。例えば、化石資源ではなく、再生可能な生物資源(バイオマス)を利用したバイオ燃料やバイオベース化学品の生産や、高い生理活性を有する機能性物質(医薬品原料、サプリメント、化粧品原料、農薬等)の高効率生産に取り組んでいます。特に、バイオ生産の核となる「スマートセル(高度に機能がデザインされ、機能の発現が制御された生物細胞)」の開発を中心とし、有用物質を高生産する微生物株の作出や、スマートセル開発に資する研究プラットフォームの構築では世界をリードしています。当分野では、社会実装に必要なブレークスルーを起こすべく、革新的な技術開発を目指して日々研究を行っています。
メンバー
蓮沼誠久 教授、田口精一 特命教授、石川周 准教授、那須野亮 特命准教授、浅水俊平 特命准教授、秀瀬涼太 特命准教授、番場崇弘 特命助教、釜阪紘平 特命助教、平山英伸 特命助手
バイオロジクス分野
バイオロジクスは、動物細胞などの生命の力を用いて生産する構造が複雑な医薬品で、近年は抗体医薬を代表とするバイオ医薬品が脚光を浴びています。
最近では、同じような方法で培養、精製、分析し、規制科学の対象になる「改変型の抗体医薬」、「遺伝子治療薬」、細胞治療用の「細胞医薬」、「mRNAワクチン・医薬」に研究の主体が移りつつあり、当部門ではこれらに着目した研究を行っています。さらには、合成品に分類されるが、複雑な構造を持つ点ではバイオロジクスと同様の研究法が適用できるペプチド医薬やナノ技術+核酸医薬にもアプローチしています。
メンバー
内田和久 特命教授、山地秀樹 教授、伊藤洋一郎 特命准教授
機能性食品・アグロバイオ分野
異常気候による農産物の生産性低減や「生活習慣病」の増加が深刻な社会問題となっている実情に鑑み、これらを解消・予防する目的で使用される「機能性食品」に関するさまざまな研究を展開しています。農畜水産物とその加工食品素材のミクロからマクロレベルの多岐なる動態を十分に考慮に入れて、画期的な農産物の生産技術や真にヒトに実効する機能性食品の開発を目指して研究に取り組んでいます。
メンバー
宇野雄一 教授、白井康仁 教授、本田和久 教授、榊原啓之 教授、水谷正治 教授、金丸研吾 准教授、橋本堂史 准教授、山下陽子 准教授、福田伊津子 助教、小山竜平 助教、林大輝 助教
出光バイオものづくり共同研究部門
本部門では、2026年を目途に特定の化合物(化粧品や将来エネルギー用途への展開の可能性がある油脂、農薬などに使用される生理活性物質など)を製造するための基盤となるスマートセルの開発を目指します。
メンバー
松井健史 特命教授